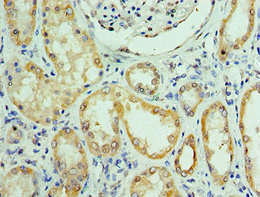

-
中文名稱:RTRAF兔多克隆抗體
-
貨號:CSB-PA896684ESR1HU
-
規格:¥440
-
圖片:
-
Western blot
All lanes: C14orf166 antibody at 6μg/ml + Mouse lung tissue
Secondary
Goat polyclonal to rabbit IgG at 1/10000 dilution
Predicted band size: 28 kDa
Observed band size: 28 kDa -
Immunohistochemistry of paraffin-embedded human liver tissue using CSB-PA896684ESR1HU at dilution of 1:100
-
Immunohistochemistry of paraffin-embedded human kidney tissue using CSB-PA896684ESR1HU at dilution of 1:100
-
-
其他:
產品詳情
-
產品名稱:Rabbit anti-Homo sapiens (Human) RTRAF Polyclonal antibody
-
Uniprot No.:
-
基因名:RTRAF
-
別名:C14orf166 antibody; CGI 99 antibody; CGI-99 antibody; CGI99 antibody; Chromosome 14 open reading frame 166 antibody; CLE antibody; CLE7 antibody; CN166_HUMAN antibody; Homeobox prox 1 antibody; LCRP369 antibody; RLL motif containing 1 antibody; RLLM1 antibody; UPF0568 protein C14orf166 antibody
-
宿主:Rabbit
-
反應種屬:Human, Mouse
-
免疫原:Recombinant Human RNA transcription, translation and transport factor protein (1-244AA)
-
免疫原種屬:Homo sapiens (Human)
-
標記方式:Non-conjugated
-
克隆類型:Polyclonal
-
抗體亞型:IgG
-
純化方式:Antigen Affinity Purified
-
濃度:It differs from different batches. Please contact us to confirm it.
-
保存緩沖液:PBS with 0.02% sodium azide, 50% glycerol, pH7.3.
-
產品提供形式:Liquid
-
應用范圍:ELISA, WB, IHC
-
推薦稀釋比:
Application Recommended Dilution WB 1:500-1:2000 IHC 1:20-1:200 -
Protocols:
-
儲存條件:Upon receipt, store at -20°C or -80°C. Avoid repeated freeze.
-
貨期:Basically, we can dispatch the products out in 1-3 working days after receiving your orders. Delivery time maybe differs from different purchasing way or location, please kindly consult your local distributors for specific delivery time.
-
用途:For Research Use Only. Not for use in diagnostic or therapeutic procedures.
相關產品
靶點詳情
-
功能:RNA-binding protein involved in modulation of mRNA transcription by Polymerase II. Component of the tRNA-splicing ligase complex and is required for tRNA ligation. May be required for RNA transport.; (Microbial infection) In case of infection by influenza virus A (IVA), is involved in viral replication.
-
基因功能參考文獻:
- C14ORF166 may represent a biomarker of pelvic lymph node metastasis in uterine cervical cancer PMID: 26219895
- C14orf166, a cellular protein required for viral replication, is incorporated into influenza virus particles. PMID: 26864902
- C14orf166 promotes bladder cancer cell proliferation and can be a novel prognostic biomarker for patients with bladder cancer. PMID: 26905879
- C14orf166 could be a novel prognostic biomarker of breast cancer, it also contributes to cell proliferation by regulating G1/S transition. PMID: 26883017
- Overexpression of chromosome 14 open reading frame 166 correlates with disease progression in nasopharyngeal carcinoma. PMID: 25964093
- Silencing of CLE causes reduction of influenza A virus polymerase activity, viral RNA transcription and replication, virus titer, and viral particle production. PMID: 21900157
- spatial interactions of hnRNPH1, NF45, and C14orf166 with HCVc174 likely modulate HCV or cellular functions during acute and chronic HCV infection PMID: 21823664
- A novel protein CGI-99 is isolated, which may be involved in the functional regulation of human ninein in the centrosome structure and may also be important in brain development and tumorigenesis. PMID: 15147888
- c14orf166 was identified asa novel metastasis-associated protein, and the roles of radixin, moesin and c14orf166 in pancreatic cancer metastasis deserve further investigations. PMID: 19152423
顯示更多
收起更多
-
亞細胞定位:Nucleus. Cytoplasm, cytosol. Cytoplasm, perinuclear region. Cytoplasm, cytoskeleton, microtubule organizing center, centrosome.; Nucleus. Cytoplasm.
-
蛋白家族:RTRAF family
-
組織特異性:Widely expressed. Expressed at high level in heart and skeletal muscle. Expressed at intermediate level in liver, pancreas, fetal brain and fetal lung. Weakly expressed in adult brain, adult lung, placenta, fetal liver and fetal kidney. Overexpressed in m
-
數據庫鏈接:
Most popular with customers
-
-
Phospho-YAP1 (S127) Recombinant Monoclonal Antibody
Applications: ELISA, WB, IHC
Species Reactivity: Human
-
-
-
-
-
-